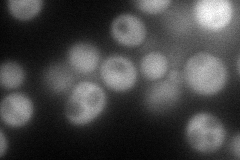
YNR029C
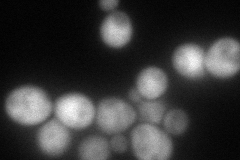
YNR029C

View description
Putative protein of unknown function, deletion confers reduced fitness in saline
Localization:
Intensity:
Fold change:
Significance:
-
C’ GFP library in SD

cytosol29.96 -
N' NOP1pr-GFP in SD
cytosol106.42 -
N' TEF2pr-mCherry in SD
cytosol102.729 -
N' NATIVEpr-GFP in SD

cytosol44.0905 -
N' TEF2pr-VC and Cyto-VN in SD

#N/A0 -
C’ GFP library in SD+DTT

cytosol32.151.07No -
C’ GFP library in SD+H2O2

cytosol30.221No -
C’ GFP library in Starvation Media

cytosol22.960.76No -
C’ GFP library on the background of Pup2-DaMP

cytosol -
C’ GFP library on the background of CCT mutant

cytosol35.99771.20128No
